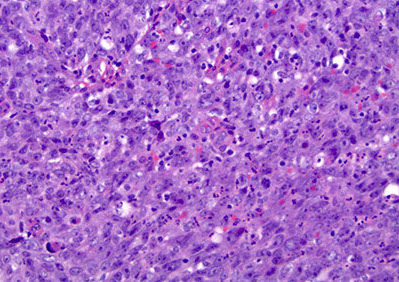

Nasopharynx
Anatomy
Histology
Allergic Fungal Sinusitis
Nasal Glioma
Nasopharyngeal angiofibroma
Sinonasal papilloma
(Sino)nasal inflammatory polyp
Sinonasal carcinoma
NUT Midline Carcinoma (NMC)
HPV-related carcinoma with adenoid cystic-like features
SMARCB1 (INI-1) deficient sinonasal carcinoma
Olfactory neuroblastoma / Esthesioneuroblastoma
Sinonasal Undifferentiated Carcinoma (SNUC)
Nasal NK/T-cell lymphoma
Nasopharynx Anatomy
Portion of the nasal passage the lies above the free border of the soft palate
- anterior wall extends from the choanae to include the incomplete floor formed by the postero-superior surface of the soft palate
- lateral walls communicate with the right and left tympanic cavities by the Eustachian tubes
Histology
lined by stratified squamous (~2/3 of the nasopharyngeal epithelium) and pseudostratified columnar respiratory-type epithelium with ciliated cells, goblet cells and basal cells
- interface bwt the 2 zones is sharp in some places with an intermediate epithelium intervening in other areas
Lots of seromucinous glands and collections of small lymphs present in the submucosa throughout the nasopharynx
- higher density at opening of eustachian tube into nasopharynx



Allergic Fungal Sinusitis
Hypersensitivity rxn to fungal antigens, not an invasive infx
- M=F; MC In kiddos and yound adults
- presents c headaches and obstructive sx
- etiology: aspergillus and diatomaceous fungi
Gross: thick rubbery mucoid material
Micro: thick eosinophilic mucus c layers of degenerated basophilic debris (degenerated eos and neuts)
- sometimes Charcot-Layden crystals
- may see fungal elements on H&E or PAS/GMS
- possibly may not see fungus

Allergic fungal sinusitis

Rhinoscleroma
Chronic infx of URT by Klebsiella pneumonia subsp. rhinoscleromatis
- M=F; seen in developing countries, esp middle east, northern/central Africa, eastern Europe
- contracted by inhaling droplets with the bacteria
3 stages of infx:
1) Rhinitic (lasts weeks)
2) Florid (granulomatous stage c mucosal thickening, obstructive sx, lasts years)
3) Fibrotic (atrophy c resolution)
Micro: inc lymphs, Russell bodies, histiocytes (Mikulicz cells) have organisms ingested
IHC: Warthin Starry silver stain can show intra-histiocytic organisms (gram negative bacteria)
Tx: Tetracycline; excision if severe and obstructive

Rhinoscleroma c subepithelial histiocytes`

Rhinosporidiosis


Rhinosporidiosis
most likely a fungal infx of URT 2/2 Rhinosporidium seeberi, seen in livestock and transmitted in water and dust
- M>F, endemic to South Asia, and South America
- sporadic in USA
- causes nasal obstruction
Micro: large (up to 300 um) sporangia in submucosa c lots of endospores
- may have thick sq mucosal epithelium, inc chronic inflam, not commonly granulomatous
DDx: coccidioidomycosis (sporangia are smaller), cylindrical cell papilloma
Tx: excision (no abx available for this organism)

Myospherulosis
Resembles fungal organisms, but is seen in pts that take nose drops
Nasal Glioma
- aka Nasal Glial Heterotopia
M=F; presents at birth or early in life (first few years) in or around nasal cavity
- 2/3 extranasal (subQ mass on nasal bridge); 1/3 intranasal (polypoid lesion c nasal obstruction); ~1/10 mixed intra/extranasal
- non-neoplastic focus of neuro tissue in extracranial sites
Gross: does not look like brain
Micro: Astrocytes and glial fibers
- gemistocytes can look like neurons, but neurons are rare
IHC: (+) S100, GFAP
DDx: r/o encephalocele (connects c cranial cavity)
Tx: excision
Px: B9
Nasal glioma


Nasopharyngeal Angiofibroma (NPAF)
- formerly juvenile angiofibroma
Uncommon, highly vascular c HPC pattern (horny vessels), b9 but aggressive and can be fatal (in 1/20)
- seen in teens, M>F (almost exclusively in males), before 25 yo, arise in posterior nasal cavity
- pts get epistaxis, headaches, nasal obstruction, proptosis, anosmia, nasal discharge
- Imaging: inc vascularity, possible erosion of bone and intracranial invasion
Gross: pink polypoid mass
micro: looks like has collagen coming off vessel
- big open vessels in collagenous stroma c fibroblasts and myofibroblasts (appear stellate and spindly)
- the tissue will usually have been embolized and lost its characteristic patterns
IHC: (+) B-catenin
Gene: del cr 17 in p53 and Her-2/neu regions
Tx: excision
Px: b9 but locally aggressive
Nasopharyngeal Angiofibroma (NPAF)





Inverted papilloma
Exophytic / Fungiform papilloma


Oncocytic papilloma
Oncocytic / cylindrical papilloma


Sinonasal papilloma
aka Schneiderian papilloma
Can detect HPV (but not EBV) with PCR
- 6/11 subtypes MC in fungiform type
- benign lesion of resp mucosa in adult men or kids c nasal stufiness, obstruction or epistaxis
- can rarely extend into cranial cavity
Usually fungiform or everted when coming from nasal septum; but MC is inverted (1/2-3/4); least common is oncocytic
The lateral wall (middle meatus or mid/inferior turbinate) are inverted with inward growth of epithelium into stroma
Can have various patterns: inverted, cylindrical cell, transitional, squamous or schneiderian
- ~1/2 are septal, a little <1/2 inverted, 1/20 cylindrical
Inverted - laterally placed on nasal wall and paranasal sinus, which dig into stroma
- has resp and sq (non-K) epithelial component c small mcus cysts, goblet cells and acute inflam in epithelium; may see mits in basal area
Micro: cells have regular arrangement c defined cell borders and maintain polarity
- look for atypia in keratinized areas (malig transformation probably focal; and can be seen in up to 1/10 cases; still just local tx if small area of malig)
Can be assoc c metachronous or synchronous carcinoma
- recur if not completely excised
Septal / Fungiform - exophytic growth of squames on septal mucosa
- see mucocytes, mucus cysts, neuts
- malig rare, areas of keratinization rare
Cyclindrical cell / Scheiderian / Oncocytic - multilayered prolif of columnar cells c eosinophilic cytoplasm and uniform nuclei; usually ciliated
- malig in <1/10; acute inflam, intraepithlial mucus cysts, and goblet cells seen
- Verrucous hyperkeratotic squamous papillomas coming from stratified squamous epithelium lining nasal vestibule excluded
Secretory cells take up IgA and IgM
DDx: respiratory epithelial carcinoma (nonK sq malig, can have glandular appearance, invasion in these cases may not be obvious, have loss of polarity, hyperchromatic nuclei, atypia, inc mits)
Usually recur (esp if inverted)
- 3% eventually turn into carcinoma (assoc c 25% survival rate)
- 3% are focally invasive in the first excision, but has an excellent prognosis
- those with malignant features have poor prog (similar to carcinoma [25%])
Tx: Excision (lateral rhinotomy + en bloc excision of lateral nasal wall and removal of all mucosa in ipsilat paranasal sinus)
- many surgeons now using CT
Sinonasal Inflammatory Polyps
Focal inflam swellings; assoc c allergy, cystic fibrosis, infx, DM, aspirin intolerance, M=F, usually bilateral
- grossly polypoid, soft, tan-grey and translucent
- can erode bone if extensive
Gross: edematous translucent tan masses
Micro: polypoid lesions, respiratory epithelial lining, has inflammation (mostly eos, lymphs, and plasma cells [not too many neutros]) coursing through a mucoid stroma,
Atypical to bizarre stromal cells of myofibroblastic origin can cause confusion c rhabdomyosarcoma
- seen in kiddos <5 yo, as a tan translucent mass; assoc c atopia, CF, DM, infx, intolerance to acetylsalicylic acid
- atypical cells distributed more regularly than rhabdomyoblasts, lack areas of variegated hypo- and hypercellularity
- surface epithlium is respiratory, sometimes c squamous metaplasia
- though can have large irregular hyperchromatic nuclei, they are of no prognostic significance
Sinonasal inflam polyp c resp epithelium (curved arrows), inc vascularity (straight arrows), edema, inflam, absent mucoserous glands
Edematous stroma c mixed chronic inflam, a mucoserous gland is present (curved arrow)


Polyp c stromal atypia and atypical cells (arrows). The cells tend to be hyperchromatic and c star-like cytoplasmic projections

Sinonasal carcinoma
>1% ca deaths in US
Predominantly left-sided
- inc risk in nickel refiners
Not much evidence for HPV/EBV involvement
MC in maxillary antrum (~1/2), vestibule and lateral wall, rarely in nasal septum
Usually dx'd late in dz, after having destroyed lots of bone and spread locally
Subtypes:
MC is inverted high-grade SCC
Cylindrical (transitional) CC is closely related to SCC and can have focal mucin production, is atypical and has stromal infiltration, loss of polarity and nuclear atypia
- these atypical features can also be found in benign lesions; can also see yolk saclike lesions
Rarely can find verrucous ca, basaloid SCC, or sarcomatoid ca, which look like they do in other organs
Sinonasal adenoca can come from the mid turbinate and relentlessly spreads locally and look like colorectal ca on micro (c goblet cells)
- do not have same genetic features as colorectal ca (K-ras, p53), and is assoc c occupational exposure
Small cell neuroendocrine ca very similar to lung type
Undifferentiated (anaplastic) ca are very aggressive (very poor px), have nests, sheets, and trabeculae
Tx - Surgery and radiation
Px - 60% 5 yr survival (stage most important factor)
- many relapse w/in 2 yrs
- adenoca subtype may have slightly better px
Undifferentiated Carcinoma (Lymphoepithlioma-Like or Nasopharyngeal-Type)
Broken down into keratinizing and nonkeratinizing (both diferentiated and undifferentiated [includes lymphoepithelioma])
- uncommon in USA, but is ~1/5 of all cancers in China, M>F, MC in lateral wall (fossa of Rosenmuller)
- assoc c high EBV titers
- grossly can be either mucosal bulge
Px: usually presents at advanced stage 2/2 location
- tend to met to LNs; undifferentiated type sens to rad
- 1/2 5-yr survival; depending on stage, pt age (younger the better), LN mets
Sinonasal undiff carcinoma c lobular growth pattern

NUT Midline Translocation Carcinoma
Rare, Small round blue cell tumor c abrupt transition to squamous epithelium
IHC: (+) CK, EMA, CD34 (var), p63, NUT
- neg: CD56, SYN, CHR, EBV,
Genes: NUT translocation confirms dx (BRD-NUT)
Px: very aggressive (~10 mo survival)
NUT midline carcinoma

Nasopharyngeal ca
Nasopharyngeal ca - EBER

Nasoparyneal Carcinoma
- subtypes: keratinizing (1/4), nonkeratinizing (1/7) or undifferentiated (3/5)
- ~1/5 cancers in China
- inc EBV titers in non-K and undiff types, no clear causal relation
- different growth patterns: Rigaud (cohesive) vs Schminke (discohesive)
Keratizing: looks like any other SCC
Nonkeratinizing (undifferentiating) subtype
- common in SE Asia and parts of Asia, younger pts usually; sometimes presenting as a neck mass
- no K, syncytial groups of large cells c pale chromatin and mprominent nucleoli, inc lymphs, no desmoplasia
- genetic and envt factors (1/5 cancers in Hong Kong), assoc c A2/sin HLA profile in chinese
- EBV assoc
- asymptomatic; neck mass
Tx: Rads (high dose) usually done 2/2 stage
- K type not responsive to rads
Px: undifferentiated has the best px (radiosensitive)
HPV-related carcinoma with adenoid cystic-like features
IHC: (+)
SMARCB1 (INI-1) deficient sinonasal carcinoma
IHC: (+)
Olfactory neuroblastoma / Esthesioneuroblastoma
neural crest origin, from NE cells of olfactory mucosa covering superior 1/3 of nasal septum, crib plate, superior turbinate
- round blue cell tumor, can have true and pseudorosettes
- F>M, peaks in 2nd and 6th decades of life, though can be found at any age and causes nasal obstruction, nasal bleeding, loss of smell, headaches
Micro: more differentiated tumors c lymphocytic-appearing infiltrate in a mesh of neuroglial fibers that appears lobular on low power
- can have Homer-Wright rosettes
- low mits, and no necrosis or pleomorphism in low-grade tumors; high grade lesions c less neurofibrillary background and can have Flexner-Wintersteiner rosettes (true neural rosettes)
IHC: (+) calretinin, SYN (10/10), NSE
- neg: S100 (only pos stromal cells, can be focal), EMA, CK (can be focal), EBV
DDx: sinonasal undifferentiated carcinoma (diffuse CK and EMA pos)
Tx: surgery and radiation
Genes: does not have 11:22 translocation
Px: depends of stage (up to 2/5 met, fairly good if not invasive)

Olfactory neuroblastoma (esthesioneuroblastoma)

Sinonasal Undifferentiated Carcinoma (SNUC)
IHC: (+) LMWK, p63 (patchy)
- neg: SYN (1/4+), EBV,
Sinonasal Melanoma
fairly rare, can look like SRBCT
Rhabdomyosarcoma
MCC of sarcoma of the head and neck
- M=F, MC in kiddos and teens
- orbit > nasopharynx > ear > sinonasal tract
-- sx depends on site
Embryonal: variegated hypo- and hypercellular areas. Cells round or spindled, hyperchromatic nuclei and may have bright eosinophilic cytoplasm (rhabdomyoblasts)
- long stap cells can be seen c cross-striation
- loss of material from short arm of Cr 11p15.5, hyperdiploid (+2q and +20)
- can have cambium layer
Alveolar : non-cohesive round tumor cells that
attach to fibrovascular meshwork causing alveolar
pattern
- sometimes solid
- rhabdomyoblasts are round cells c eosinophilic
cytoplasm; some tumor cells multinucleated c
peripheral nuclei, similar to sk muscle cells
Genes: translocation bwt FKHR gene on cr 13 and either PAX3 gene on cr 2 (7/10 ) or the PAX7 gene on cr 1 (1/3)
- pts c PAX7 translocation usually younger and can see longer event-free survival than pts c PAX3 translocation.
- unlike embryonal RMS, alveolar RMS commonly demonstrates gene amplification, and its DNA content typically tetraploidy.
Pleomorphic rhabdomyosarcoma - very rare
- Mixed patterns may occur
IHC: (+) Desmin, Myo D1, myoglobin, actin
Tx: Nonradical excision, rads and chemo
Px: In stage I dz– 80% 5-year survival; if
residual microscopic disease or regional nodes involved – 70%; if gross residual disease – 52%; if distant mets – 20%. Orbital tumors are more favorable than nonorbital H&N tumors.
Embryonal RMS, nasal cavity


Angiocentric T-cell lymphoma (NT/NKCL)
- formerly “lethal midline granuloma.”
Nasal T-cell/natural killer cell lymphomas characterized by extensive facial swelling, deformity,
ulceration and necrosis. Nasal septal perforation and
collapse of the nasal bridge may occur
-largely 2/2 angiocentric tendency of these lymphomas
- classic features: angiocentricity with massive
necrosis
- angiocentricity is not required to dx
- T-cell lymphomas are much more common in Asia and South America than in the US, where sinonasal
lymphomas are about half T-cell and half B-cell types
Micro: spectrum is wide small, medium, or large cells, or a mixture of cell types
- mixed pattern may be mistaken for reactive inflammatory infiltrate
IHC: (+) EBV, CD56, CD45/2/3e(cytoplasmic), perforins
- neg: EMA, CK, SYN, CHR, pan-T cell markers (CD3)
Genes: FISH >80% c EBV assoc nuclear
RNA (EBER)
Px: linked to stage, but T-cell sinonasal lymphomas
had, after radiotherapy, 5 – and 15-year survivals of 63% and 50%. NT/NKCL patients may develop
hemophagocytic syndrome.
Extranodal NK/T cell lymphoma, nasal type


Sinonasal adenocarcinoma
Rare, except for the salivary gland AC, M > F, 6th decade, presents c nasal obstruction or bleeding
Low-grade Ac: very bland with well-formed
glands
- can be mistaken for b9 process
- Look for back to back glands and deep extension
- occur in younger pts ,have excellent px
High grade: SNUC, poorly diff AC, NOS, or intestinal-type adenocarcinomas
- Intestinal type resembles colonic carcinoma and includes mucinous and signet ring types as
well as the more typical tubular and papillary patterns.
- seen in older pts, may be assoc c occupational exposures such as the furniture and shoe
industries (wood dust and leather processing)
- very poor px (20% three-year survivals)
Low-grade Sinonasal Adenocarcinoma

High-grade Sinonasal Adenocarcinoma

Cystic metastatic squamous cell carcinoma
Lymph node metastases of SCC c cystic degen
- can be mistaken for branchial cleft cysts or malign change in a branchial cleft cyst (which never
happens)
- epithelium mostly nonkeratinizing and look like CIS
- can be distinguished from epithelium of
branchial cleft cyst by high mitotic rate, nuclear atypia, loss of cell polarity and areas of infiltrative pattern.
- look for the architecture of the node: subcapsular sinus and sinusoids – branchial cleft cysts do not have these
Advise surgeon of the morphology and suggest
searching the Waldeyer’s ring area and possible ipsilateral tonsillectomy
- primary may be very tiny; some are not found until years after the positive node
- often have better px than other SCC even just with
removal of the positive node.
Lots of pathologists get sued for these, send off if not completely sure!!!
Cystic metastatic SCC

Sinonasal Hemangiopericytoma (HPC)
Vascular lesion thought to come from pericytes (baroreceptor cells)
- ~1/4 HPCs arise in the head and neck, M=F, usually in adults in nasal cavity and sinuses
- present c epistaxis and nasal obstruction
Micro: staghorn vessels
IHC: (+) reticulin fibers around individual cells, staining pattern more like a glomus tumor
- neg: CD34
Px: better px if from sinonasal site (~1/5 recur) vs other sites (~1/2 recur)
- more often malig if inc mits (>1 / 10 hpf), necrosis, destructive or invasive pattern, mets


Sinonasal HPC
Sinonasal glomangiopericytoma
Micro: tumor with uniform spindle cells with small dark nuclei surrounding small blood vessels.
- Numerous blood vessels show hyalinized walls
IHC: (+) SMA, B-catenin
- negative S100, CD34
Px: 20% local recurrence, only rare mets documented


sinonasal glomangiopericytoma
sinonasal glomangiopericytoma
1 - 2
<
>
References
1. Histology and anatomy from https://www.proteinatlas.org
2. Notes: Osler course
